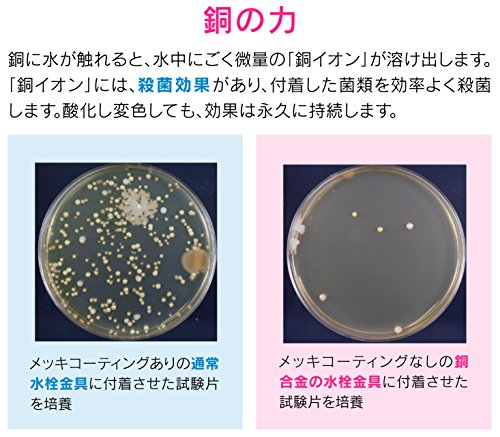
main

販売情報
画面をスクロールすると販売情報が更新されます。
最終更新:
最安値ショップ
最安値ショッピングサイト
実質価格ランキング
商品情報






直径:144ミリ×厚み:17ミリ 素材・材質:銅 生産国:日本 使用を重ねるうちに黒ずんでいき、しだいに薄青みがかった皮膜に変色しますが、銅イオンの殺菌効果は変わりません。
| JANコード | 4972353801534 |
|---|---|
| 型番 | GA-PB002 |
| メーカー | GAONA(ガオナ) |
| ブランド | GAONA(ガオナ) |
画面をスクロールすると販売情報が更新されます。

直径:144ミリ×厚み:17ミリ 素材・材質:銅 生産国:日本 使用を重ねるうちに黒ずんでいき、しだいに薄青みがかった皮膜に変色しますが、銅イオンの殺菌効果は変わりません。
| JANコード | 4972353801534 |
|---|---|
| 型番 | GA-PB002 |
| メーカー | GAONA(ガオナ) |
| ブランド | GAONA(ガオナ) |